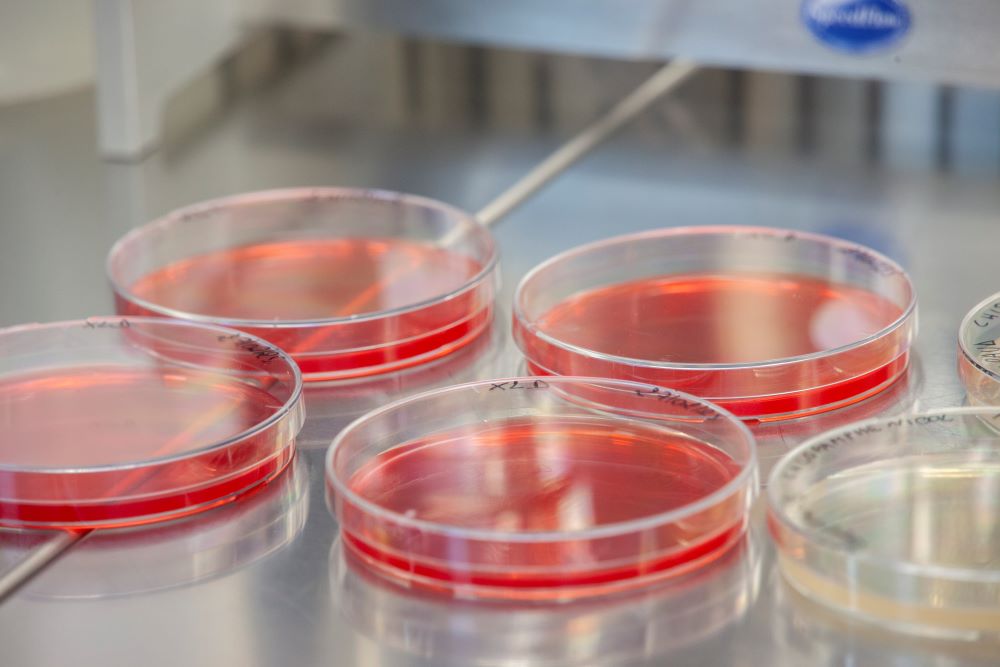

Standard nazionali ed internazionali materie prime e prodotti finiti
In ambito chimico e microbiologico al servizio delle aziende
Servizi
Scopri le nostre divisioni e consulenze
Spedizioni
Viesselab è dotato di una logistica ben organizzata per il ritiro dei campioni su tutto il territorio nazionale con consegna dei campioni in 24-48 h
I soci fondatori
Davide Soricelli
Chimico
Esperienza pluriennale di Controllo Qualità, Stabilità e Convalida in ambito Farmaceutico. Esperienza pluriennale di Responsabile della Qualità in azienda produttrice di Integratore alimentare, Dispositivo medico e Cosmetico. Owner del processo ispettivo riguardante ISO 9001, GMP Food, marcatura CE DM.
Antonio Viola
Biologo
Esperienza consolidata in ambito agroalimentare, sicurezza e igiene alimentare (compresa ricerca di pesticidi in LC/GC-MS), HACCP, supporto analitico nella gestione della qualità dei prodotti, nelle attività di import/export e competenze nell’analisi di Materiali ed Oggetti destinati al Contatto con Alimenti (MOCA), consulenza in generale. Comprovata esperienza in ambito Controllo Qualità Microbiologico (patogeni e non).
Alessia Viola
Chimico
Esperienza pluriennale in ambito Controllo Qualità Farmaceutico con impiego di tutte le tecniche analitiche all’avanguardia. Esperienza pluriennale in ambito R&D Analitico con sviluppo e convalida di Metodi Analitici di svariata complessità (HPLC-MS, GC-MS, HPLC-UV-DAD-RID, UV-Vis, IR, PCR, ELISA, GC-FID, HSGC, ecc).
I SOCI FONDATORI
Come nasce Viesselab
Davide Soricelli
Chimico farmaceutico abilitato chimico
Esperienza pluriennale di Controllo Qualità, Stabilità e Convalida in ambito Farmaceutico. Esperienza pluriennale di Responsabile della Qualità in azienda produttrice di Integratore alimentare, Dispositivo medico e Cosmetico. Owner del processo ispettivo riguardante ISO 9001, GMP Food, marcatura CE DM.
Antonio Viola
Biologo abilitato
Esperienza consolidata in ambito agroalimentare, sicurezza e igiene alimentare (compresa ricerca di pesticidi in LC/GC-MS), HACCP, supporto analitico nella gestione della qualità dei prodotti, nelle attività di import/export e competenze nell’analisi di Materiali ed Oggetti destinati al Contatto con Alimenti (MOCA), consulenza in generale. Comprovata esperienza in ambito Controllo Qualità Microbiologico (patogeni e non).
Laboratorio chimico e microbiologico
Tecnologia e strumenti all'avanguardia
Hai bisogno di aiuto e di maggiori informazioni?
i nostri numeri
Cosa abbiamo fatto in questi anni
Gallery

News
Approfondisci le nostre ultime notizie
10
Anni di esperienza
25
Aziende servite
80
Macchinari
80
Tipologie analisi